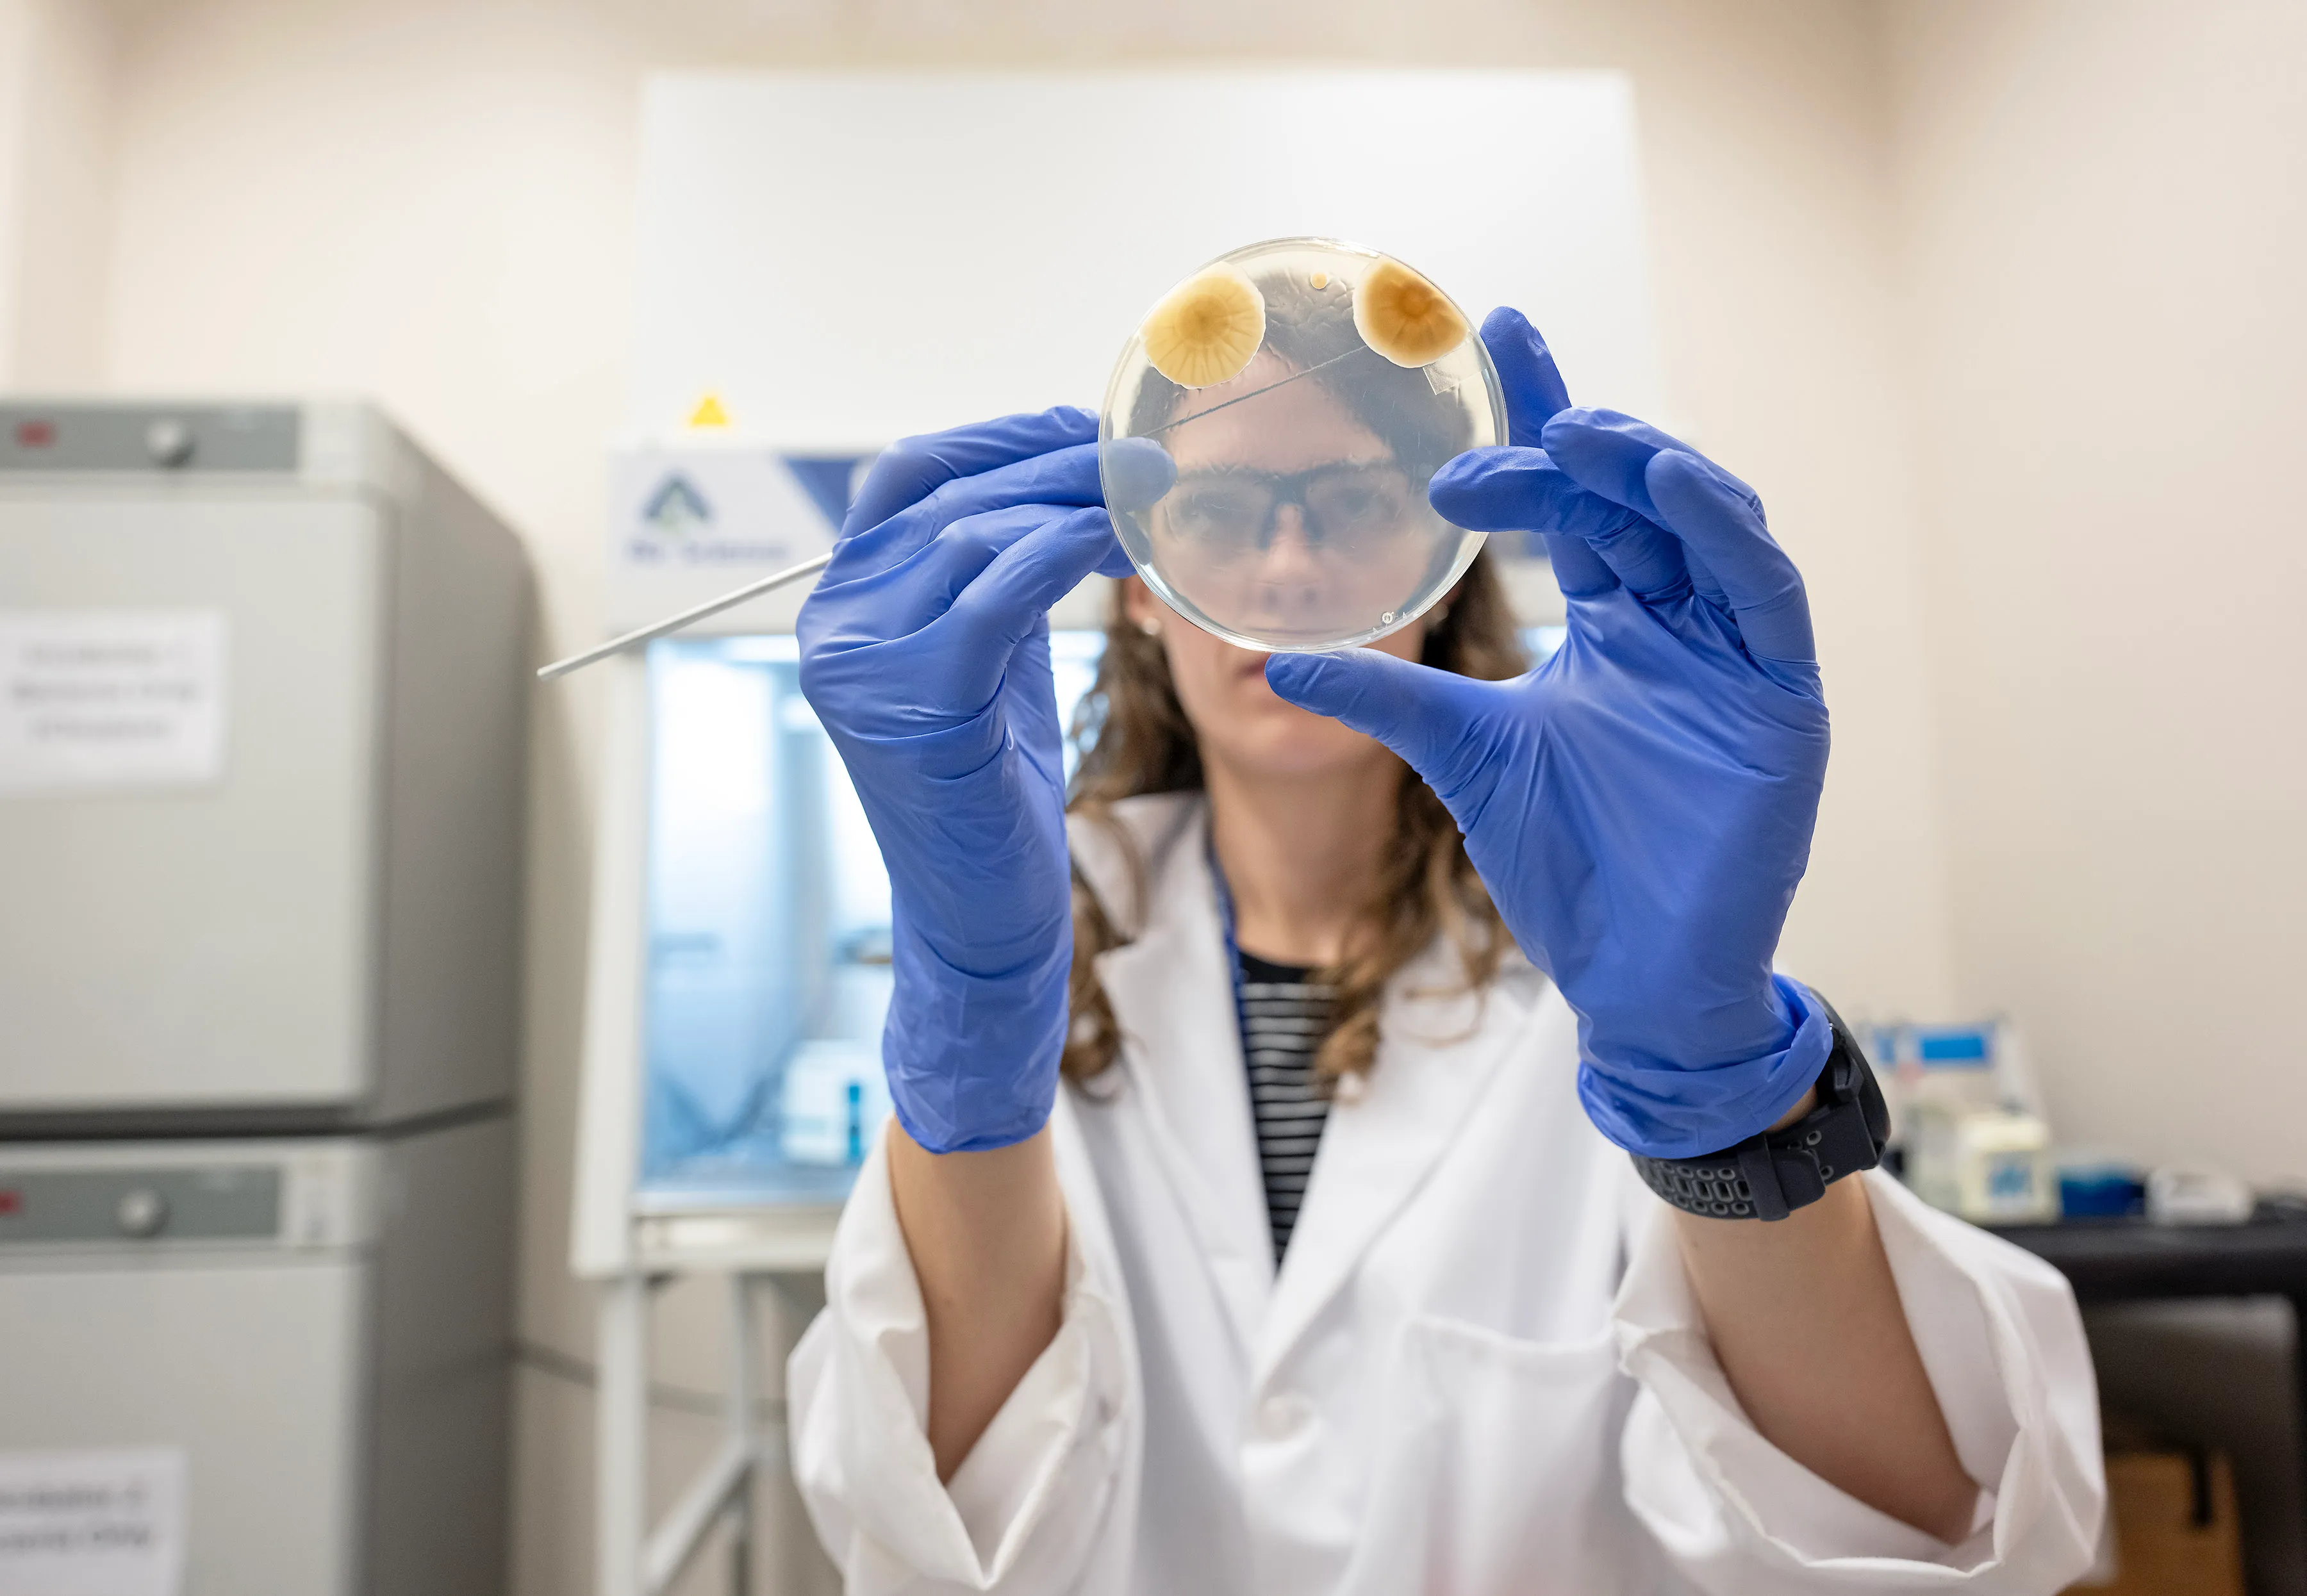

Search
Items tagged with: marshallspaceflightcenter

Shuttle, Family Inspire NASA’s Cryogenic Technology Manager - NASA
Jeremy Kenny, NASA’s Cryogenic Technology Manager finds inspiration from his family and the past Space Shuttle program.Beth Ridgeway (NASA)

NASA's Chandra Identifies an Underachieving Black Hole - NASA
This image shows a quasar, a rapidly growing supermassive black hole, which is not achieving what astronomers would expect from it, as reported inNASA

NASA Artemis Mission Progresses with SpaceX Starship Test Flight - NASA
As part of NASA’s Artemis campaign to return humans to the Moon for the benefit of all, the agency is working with SpaceX to develop the company’s StarshipLee Mohon (NASA)

NASA Lights ‘Beacon’ on Moon With Autonomous Navigation System Test - NASA
For 30 total minutes in February, NASA lit a beacon on the Moon. Delivered to the lunar surface Feb. 22 via the Odyssey lander, NASA’s Lunar Node-1 experiment successfully demonstrated a new navigation and positioning system that will change how spac…Beth Ridgeway (NASA)

Evolved Adapter for Future NASA SLS Flights Readied for Testing - NASA
A test version of the universal stage adapter for NASA’s more powerful version of its SLS (Space Launch System) rocket arrived to Building 4619 at NASA’sNASA

NASA Continues Artemis Moon Rocket Engine Test Series - NASA
NASA conducted a full-duration RS-25 engine hot fire March 6, continuing a final round of certification testing for production of new engines to help power the SLS (Space Launch System) rocket on future Artemis missions to the Moon and beyond.NASA

The Marshall Star for February 28, 2024 - NASA
For the first time in more than 50 years, new NASA science instruments and technology demonstrations are operating on the Moon following the first successfulLee Mohon (NASA)

NASA, SpaceX Test Starship Lunar Lander Docking System - NASA
As part of NASA’s Artemis campaign that will establish the foundation for long-term scientific exploration at the Moon, crew will need to move betweenNASA

Listen to the Universe: New NASA Sonifications and Documentary - NASA
Three new sonifications of images from NASA’s Chandra X-ray Observatory and other telescopes have been released in conjunction with a new documentary aboutLee Mohon (NASA)

Former Student Launch Competitor Turns Experience into NASA Engineering Career - NASA
Meredith Patterson, an aerospace engineer at NASA’s Marshall Space Flight Center in Huntsville, Alabama, started her rocket journey with the Student Launch competition to being part of the team that is working to put humans back on the Moon.Beth Ridgeway (NASA)

Former Student Launch Competitor Turns Experience into NASA Engineering Career - NASA
Meredith Patterson, an aerospace engineer at NASA’s Marshall Space Flight Center in Huntsville, Alabama, started her rocket journey with the Student Launch competition to being part of the team that is working to put humans back on the Moon.Beth Ridgeway (NASA)

I Am Artemis: Josh Whitehead - NASA
Launching a rocket to the Moon takes perseverance and diligence. Josh Whitehead – a world-class engineer, race-winning long-distance runner, and father –NASA
NASA’s Planetary Protection Team Conducts Vital Research for Deep Space Missions - NASA
As NASA continues its exploration of the solar system, including future crewed missions to Mars, experts in the agency’s Office of Planetary Protection are developing advanced tactics to prevent NASA expeditions from introducing biological contaminan…Beth Ridgeway (NASA)

NASA to Continue Testing for New Artemis Moon Rocket Engines - NASA
NASA will conduct an RS-25 hot fire Friday, Feb. 23, moving one step closer to production of new engines that will help power the agency’s SLS (Space LaunchLaToya Dean (NASA)

Stellar Beads on a String - NASA
Astronomers have discovered one of the most powerful eruptions from a black hole ever recorded in the system known as SDSS J1531+3414 (SDSS J1531 for short).NASA

Stellar Beads on a String - NASA
Astronomers have discovered one of the most powerful eruptions from a black hole ever recorded in the system known as SDSS J1531+3414 (SDSS J1531 for short).NASA

Rocket Propellant Tanks for NASA’s Artemis III Mission Take Shape - NASA
As NASA works to develop all the systems needed to return astronauts to the Moon under its Artemis campaign for the benefit of all, the SLS (Space LaunchLee Mohon (NASA)

Teams Add Iconic NASA ‘Worm’ Logo to Artemis II Rocket, Spacecraft - NASA
Art and science merge as teams add the NASA “worm” logo on the SLS (Space Launch System) solid rocket boosters and the Orion spacecraft’s crew module adapterElyna N. Niles-Carnes (NASA)

NASA Artemis Science, First Intuitive Machines Flight Head to Moon - NASA
A suite of NASA science instruments and technology demonstrations is on the way to our nearest celestial neighbor for the benefit of humanity. Through thisNASA

NASA Solar Sail Technology Passes Crucial Deployment Test - NASA
NASA continues to unfurl plans for solar sail technology as a promising method of deep space transportation. The agency cleared a key technology milestone in January with the successful deployment of one of four identical solar sail quadrants.Beth Ridgeway (NASA)

NASA Marshall Invites Media to Meet New Center Director - NASA
The media is invited to NASA Marshall to meet speak to the new Marshall Space Flight Center Director, Joseph PelfreyNASA

Rahul Ramachandran Essay Published on NASA’s EarthData - NASA
Rahul Ramachandran (ST11) wrote his American Geophysical Union (AGU) Leptoukh lecture as an essay titled “From petabytes to Insights: Tackling EarthNASA

Telescopes Show the Milky Way's Black Hole is Ready for a Kick - NASA
This artist’s illustration depicts the findings of a new study about the supermassive black hole at the center of our galaxy called Sagittarius A*NASA

The Marshall Star for February 7, 2024 - NASA
NASA Administrator Bill Nelson on Feb. 5 named Joseph Pelfrey director of the agency’s Marshall Space Flight Center, effective immediately. Pelfrey has servedLee Mohon (NASA)

NASA to Demonstrate Autonomous Navigation System on Moon - NASA
The Lunar Node-1 experiment, set to launch on the second Commercial Lunar Payload Services (CLPS) delivery to the Moon, will conduct an experiment that could change how humans, rovers, and spacecraft track their lunar exploration missions.Beth Ridgeway (NASA)

NASA Administrator Announces New Marshall Space Flight Center Director - NASA
NASA Administrator Bill Nelson on Monday named Joseph Pelfrey director of the agency’s Marshall Space Flight Center in Huntsville, Alabama, effectiveNASA

NASA Taps Alabama A&M University to Host Break the Ice Lunar Challenge - NASA
Break the Ice, a NASA Centennial Challenges competition, will host the last round of testing and trials at Alabama A&M University in Huntsville, Alabama this summer.Beth Ridgeway (NASA)

NASA Marks Halfway Point for Artemis Moon Rocket Engine Certification Series - NASA
The current series builds on previous hot fire testing conducted at NASA Stennis to help certify production of new RS-25 engines by lead contractor AerojetLaToya Dean (NASA)

I Am Artemis: Erick Holsonback - NASA
Whether he’s advising student robotic competitions or managing production of a powerful, new Moon rocket stage, Erick Holsonback meets technical challengesNASA

NASA Continues Artemis Moon Rocket Engine Tests with 1st Hot Fire of 2024 - NASA
NASA continued a critical test series for future flights of NASA’s SLS (Space Launch System) rocket in support of the Artemis campaign on Jan. 17 with aNASA

NASA’s IXPE Helps Researchers Maximize ‘Microquasar’ Findings - NASA
Researchers using data from NASA’s Imaging X-ray Polarimetry Explorer to study a microquasar – a distant black hole stripping a companion star of material – have published new findings about how cosmic-ray particles streaming away from the microquasa…Beth Ridgeway (NASA)









